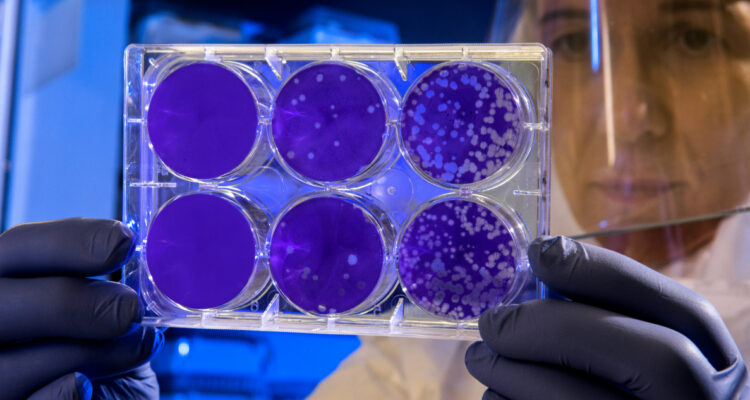
Imagen referencial de un laboratorio con bacterias

Una inteligencia artificial (IA) desarrollada por Google sorprendió al resolver un misterio sobre las superbacterias en solo dos días, se trata del desarrollo de una compleja hipótesis que a los científicos les tomó varios años.
El microbiólogo José R. Penadés y su equipo del Imperial College de Londres estuvieron una década estudiando cómo se crean algunas superbacterias y para que pudieran formar una hipótesis viable pasaron años.
En entrevista con BBC News, Penadés contó que le entregó una pregunta central a la IA sobre el planteamiento que estuvo investigando y en solo 48 horas obtuvo la misma respuesta que consiguió él.
Su sorpresa fue tal que consultó a Google si es que de alguna forma tenían acceso a su computador o sus datos, ya que no ha publicado su investigación aún, pero la compañía lo negó. Además, la IA llegó más allá.
“No es solo que la hipótesis principal que ofrece fuera la correcta. Es que ofrece otras cuatro y todas tenían sentido. Y en el caso de una de ellas, nunca la habíamos pensado, y ahora la estamos trabajando“, explicó.
La hipótesis que baraja el experto en microbiología es que las superbacterias, que son gérmenes peligrosos y resistentes a los antibióticos, pueden formar una especie de cola a partir de diferentes virus, lo que les permite propagarse.
De acuerdo con Penadés, él y su equipo eran los únicos que planteaban esta hipótesis y la IA llegó al mismo resultado. “Estoy ante algo espectacular y estoy muy contento de ser parte de eso”, manifestó.
Una IA para los científicos
Se llama “co-scientist” y fue presentada a mediados de febrero por Google, con el objetivo de “ayudar a los científicos a generar nuevas hipótesis y propuestas de investigación, y para acelerar la velocidad del reloj de los descubrimientos científicos y biomédicos“, manifestó la compañía en un comunicado.
El modelo está “diseñado para reflejar el proceso de razonamiento que sustenta el método científico“, señalan. De hecho, puede llegar más allá de la revisión de literatura científica o generar resúmenes.
“Está destinado a descubrir conocimientos nuevos y originales y formular hipótesis y propuestas de investigación demostrablemente novedosas, basándose en evidencia previa y adaptadas a objetivos de investigación específicos”, dice Google.
co-scientist utiliza un conjunto de agentes especializados, que incluyen generación, reflexión, clasificación, evolución, proximidad y meta-revisión, que usa retroalimentación automatizada para generar, evaluar y refinar hipótesis.
Si bien las capacidades que pueden alcanzar las IA aún están en debate, Penadés se mostró entusiasta con la idea de un apoyo como este, ya que si hubiera conseguido esa hipótesis tan rápido como hizo el modelo, podrían haberse ahorrado años de investigaciones.
Sin embargo, también están quienes opinan que el uso deliberado de la IA puede ser perjudicial o incluso quitar puestos de trabajo. “Creo que esto cambiará la ciencia, sin duda”, dijo.







 Enviando corrección, espere un momento...
Enviando corrección, espere un momento...